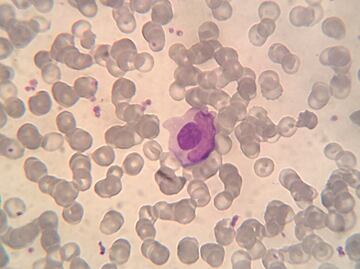
Una mutación genética, posible causante de la enfermedad del lupus

Más Información
¿Cuándo se estrena la serie de Harry Potter en HBO Max?; primer tráiler revela fecha, guiños y claves

Brozo y Loret exhiben “lujo" en Palacio Nacional; acusan que se “asolean” desde el balcón mientras arde Dos Bocas
"Mens sana in corpore sano". A menudo usamos esta cita para reivindicar el efecto beneficioso de la actividad física en las capacidades mentales. En realidad, la frase apareció en la "Sátira X" escrita por el cómico romano Juvenal allá por el siglo II y era más extensa: indicaba que había que orar para disponer de un espíritu sano en un cuerpo sano ("orandum est ut sit mens sana in corpore sano").
¿Pero es cierto eso de que mantener el cuerpo sano, equilibrado y ejercitado ayuda a mantener las capacidades mentales de nuestro cerebro? Pues sí, y hay muchas evidencias científicas que lo demuestran, especialmente en lo que se refiere al envejecimiento.
El cerebro pierde volumen durante el envejecimiento
A medida que cumplimos años, los tejidos y los órganos se degeneran. La capacidad de mantener la función de las células va disminuyendo y eso se acompaña de una pérdida de tejido. En el cerebro también ocurre, con la consiguiente neurodegeneración o pérdida de neuronas.
Lee también: ¿Eres adicta o adicto a la comida? Identifican a la molécula culpable
Ya sea en patologías como la enfermedad de Alzheimer o en la pérdida de funcionalidad debida al envejecimiento, en el cerebro se producen diferentes cambios asociados a la perdida de función. Entre ellos, adelgazamiento de la zona cortical, pérdida de tejido gris (cuerpos neuronales) y blanco (conducciones nerviosas), aumento del volumen de los ventrículos (huecos dentro del cerebro donde está el líquido cefalorraquídeo) y disminución de neuronas en diferentes zonas, especialmente en el hipocampo.

Si reducir la capacidad metabólica implica pérdida de volumen cerebral, podemos deducir que una mejor utilización de la energía mediante la práctica del ejercicio podría ralentizar la pérdida de tejido en el cerebro.
Más ejercicio, más memoria
¿Es así? Responderlo no es sencillo. Sobre todo, porque uno de los principales escollos que nos encontramos a la hora de determinar el efecto de cualquier intervención sobre el cerebro es la práctica imposibilidad de comprobar rápidamente sus consecuencias.
El cerebro no es como la sangre o el músculo, que rápidamente muestran una respuesta fácilmente medible de manera directa o a partir de componentes sanguíneos. Lo bueno es que la llegada de métodos de imagen cada vez más fiables está permitiendo detectar algunas modificaciones estructurales en ciertas zonas del cerebro.
Hace ya tiempo que tenemos indicios de que la práctica de ejercicio físico mejora la capacidad cognitiva e incrementa el tamaño de determinadas áreas del cerebro, especialmente de las relacionadas con la memoria.
Por ejemplo, en 2011 se publicó un artículo en "PNAS" (Documentos de la Academia Nacional de Ciencias de EU) donde se indicaba que el ejercicio físico aumentaba el volumen del hipocampo, la sección del cerebro donde reside la memoria. En otros estudios, en personas mayores se demostró que el ejercicio físico también prevenía la pérdida de volumen en esta zona del cerebro.
Metabolismo, señalización y hormesis: claves para mantener la actividad
Tendemos a considerar a nuestro organismo como un sistema compartimentalizado. Si tenemos un problema en el hígado, focalizamos en el hígado, y si es en el riñón, pues en el riñón. Pero nuestro cuerpo no funciona así: todo está interconectado. Por eso un problema de riñón puede acabar agravando una cardiopatía, o un problema hepático provocar una isquemia cerebral. En el envejecimiento en concreto, los complejos equilibrios corporales se encuentran en una situación muy precaria.
Cuando nos ejercitamos sometemos a nuestro cuerpo a un estrés moderado, ya que obligamos a las células a aumentar el gasto energético. Eso implica movilizar nutrientes, que deben pasar desde los almacenes a los músculos. A todos los cambios fisiológicos necesarios para hacer frente a este estrés moderado se les conoce como hormesis.
En el proceso de hormesis, los músculos liberan sustancias que informan al resto de los órganos de que aumenta la demanda energética. Estas sustancias reciben el nombre de mioquinas y se liberan a la sangre, que las distribuye al resto de órganos.
Algunas de esas mioquinas alcanzan el cerebro y allí inducen la expresión de genes y proteínas que aumentan la capacidad de las neuronas para establecer nuevas conexiones o reforzar las ya existentes.
Una de esas mioquinas es la denominada BDNF (factor neurotrófico derivado del cerebro), esencial para que las neuronas establezcan conexiones y así mantenerlas activas. De esta manera tan simple podemos explicar por qué el ejercicio físico mantiene el volumen cerebral durante el envejecimiento.
Lee también: Amber Heard. ¿Cuáles son y cómo identificar los trastornos mentales que padece la actriz?
Por otro lado, el ejercicio físico también incrementa el flujo sanguíneo y la oxigenación, lo que repercute positivamente en la actividad cerebral también en personas mayores. Además, otros estudios han demostrado que el ejercicio físico moderado produce efectos antiinflamatorios que pueden generar efectos en el cerebro, por ejemplo, reduciendo así la progresión del Alzhéimer o la demencia senil.
Las evidencias científicas, tanto directas como indirectas, dejan claro que practicar actividad física al envejecer ayuda a prevenir la degeneración del cerebro, dando todo el sentido a la frase "mens sana in corpore sano".
Más nos vale evitar la inactividad y el sedentarismo si queremos añadir vida a los años y no solo años a la vida.
melc
Noticias según tus intereses
[Publicidad]
[Publicidad]